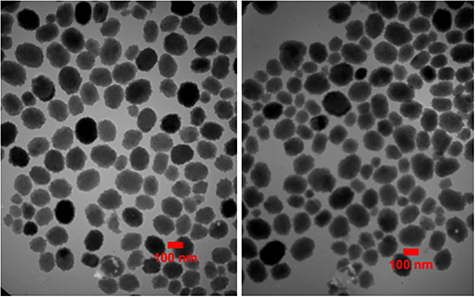
Figure 2.

Abstract
The ability of biofilm formation in methicillin-resistant Staphylococcus aureus (MRSA) causes significant mortality and morbidity in wound infections. Nanoparticles because of the drug concentration increment at the point of contact of nanoparticles and bacteria, and slower release of the drug at the desired location are considered as proper tools to overcome the therapeutic problem of antimicrobial-resistant infections. This study was aimed to evaluate the anti-biofilm activity of cefazolin-loaded nanoparticles against MRSA isolates. The 27 clinical isolates of MRSA were collected from patients with pressure sores and diabetic ulcers referred to Loghman Hospital in Tehran—Iran. MRSA isolates were detected by polymerase chain reaction (PCR) and biochemical tests. Cefazolin-loaded niosome was synthesized using the thin-film hydration method and were characterized by zeta potential measurement and transmission electron microscopy (TEM). The round-shaped cefazolin-loaded niosomes had a diameter of 100 nm and a −63 mV zeta potential. The cefazolin-containing niosomes removed 1, 3, and 5 d old biofilms at the concentration of 128 µg ml−1, 128 µg ml−1, and 256 µg ml−1, respectively. Histological results indicated that BALB/c mice receiving cefazolin-loaded niosomes were treated effectively faster than those treated by cefazolin or untreated group. In conclusion, the cefazolin-loaded niosome could be considered as a promising candidate for the treatment of biofilm-mediated infections of MRSA.
Export citation and abstract BibTeX RIS
1. Introduction
Chronic wounds are defined as skin injuries with a prolonged healing process (approximately more than 1 month), and it is revealed that these wounds/ulcers are hard-to-heal or difficult-to-heal due to the disruption in the complex and interactive processes of healing, for instance hemostasis, inflammation, proliferation, or remodeling phases [1]. These wounds can be categorized based on their location, age, and comorbidity of other conditions such as diabetes, neuropathy, vascular disease, and wounds resulting from surgical interventions and trauma [2]. Understanding the diverse etiology of chronic wounds involving skin physiology, the healing cascade, and genetic regulators are needed for establishing improved treatment options for wound care and management. Chronic wounds pose significant humanistic and economic burdens both at an individual and a societal level, causing significant pain, immobility, and decreased quality of life for the patient; as well as increased healthcare costs due to the prolonged hospitalization, clinical interventions, and treatments [3]. An analysis of Medicare beneficiaries in 2018 identified about 8.2 million people who suffered from wounds with or without infections whereas the Medicare costs estimates $28.1 billion to $96.8 billion for acute and chronic wounds [4]. Therefore, plenty of wound care products have been created and developed in the latest decades aimed at promoting wound healing and improving the life quality of the patients afflicted by skin wounds [2, 5–7]. Long-term bacterial infections are characteristic of chronic wounds [8]. Pathogenic bacteria present in biofilm use host nutrients in the inflammatory microenvironment and contribute to the damaging of the host tissue [9]. Conventional antibiotic therapies such as using proton pump inhibitors (omeprazole, lansoprazole, esomeprazole), H2 Receptor Blockers (cimetidine, famotidine), etc are not effective, as the extracellular polysaccharide matrix of biofilms protect bacterial accumulations from the immune system and concurrently avoid antibiotic penetration [10]. Additionally, biofilm formation delays the healing processes and leads to chronic infection resulting in medical complications [11]. The high infection and death toll is due to the extraordinary resistance of biofilms to antimicrobial agents. It is revealed that principal wound pathogens Staphylococcus aureus, and Pseudomonas aeruginosa are among the most common organisms isolated from both acute and chronic wounds. Methicillin-resistant S. aureus (MRSA), and their ability to form biofilms in wounds are considered as the major causes of wound treatment failure [12]. Bacterial communities living in a biofilm are considered 10–1000 times more resistant to antibiotics than free cells [13]. MRSA poses a high potential for biofilm formation and mediates life-threatening nosocomial infections with serious health consequences [14]. Therefore, the elimination of staphylococcal biofilm will definitely decrease the mortality and morbidity of MRSA [15]. Cefazolin has become the first choice for the treatment of S. aureus infections and is routinely prescribed as surgical prophylaxis in patients with previous/high risk of MRSA infections [16]. Therefore, antimicrobial therapy against MRSA is complicated. Cefazolin has shown positive effects against staphylococcal infection and has been recommended for bone and joint infection in some studies [17]. However, high microbial resistance against cefazolin has been reported in biofilm-producing S. aureus [18]. It is proven that cefazolin significantly reduces morbidity and mortality rates with a lower chance of recurrent bacteremia, anaphylactic shock, and toxicity [19]. However, the efficacy of cefazolin therapy against MRSA has been reduced due to drug delivery problems mediated by the extracellular polymeric matrix of staphylococcal biofilm. Vesicular systems can facilitate antibiotics penetration and reduces drug delivery problems. Niosomes have been studied for antibiotic treatment and shown satisfactory results in reducing antibiotic dosages and specific drug delivery in various studies [20]. Niosomes are self-assembly bilayer nonionic surfactant-based vesicles that are commonly used for drug, gene, and protein delivery as a result of their encapsulating capability of hydrophilic and hydrophobic components [21]. Furthermore, their capability to release the drug in a controlled manner minimizes the required drug dosage which ultimately results in side effects reduction [21, 22]. In our study, the efficacy of cefazolin-loaded niosomes against staphylococcal wound infection has been evaluated. One way to enhance the efficacy of antibiotic treatment in such biofilm-associated infections is to modify the drug delivery system. Vesicular systems are considered promising tools for more effective antimicrobial delivery. Nano-formulations such as liposomes and niosomes can deliver a large scale of drugs due to their physical and chemical features [23, 24]. Niosomes are biocompatible, biodegradable, and non-immunogenic and have improved the disadvantages of liposomes by lower cost, physiochemical stability, and easier handling [25–27]. The ability to reduce clearance rate, drug protection, and targeting specific sites as well as providing various administration routes including oral, topical, ocular, etc make them appropriate systems for therapeutic goals [24, 28]. In this study, cefazolin-containing nanoparticles were synthesized, and their morphological features as well as their entrapment efficacy, cell viability, drug delivery were characterized. Moreover, the anti-staphylococcal biofilm formation of cefazolin-loaded niosomes and their skin regeneration properties against wound infection were evaluated.
2. Material and methods
2.1. Bacterial strains
Samples were collected from patients hospitalized at Loghman hospital, Tehran, Iran from November of 2018 to January of 2019. Eighty wound exudate samples were collected from patients with diabetic foot ulcers and pressure ulcers using a swabbing technique and transferred to Pasteur Institute of Iran. Isolates were initially diagnosed as S. aureus following biochemical tests [1]. Antibiotic susceptibility testing against Cefoxitin 30 µg was performed by the disk diffusion method using the Clinical and Laboratory Standards Institute. Standard S. aureus (ATTCC25923) and MRSA (ATCC6538) were used as the control samples in identification and susceptibility experiments.
2.2. MecA gene identification
Bacterial DNA was extracted from Cefoxitin-resistant S. aureus isolates using a DNA extraction kit according to the manufacturer's recommendations (Qiagen, Hilden, Germany). The final reaction volume was 25 µl containing 10 μl sterile distilled water, 12 μl of Taq DNA Polymerase Master Mix RED (AMPLIQON, Denmark), 1 μl of forward and reverse mecA primers (BIO NEER, Korea), and 1 μl of bacterial DNA. Polymerase chain reaction (PCR) amplification of mecA gene, (which allow the detection and production of large amounts of DNA), was carried out using GenePro thermal cycler (Bioer Technology, China) under the condition of initial denaturation at 94 °C for 4 min, followed by 30 cycles at 94 °C for 45 s, 58.5 °C for 45 s, and 72 °C for 1 min, with a final extension step of 72 °C for 3 min. PCR products were electrophoresed on 1.5% agarose gel (SIGMA, USA), stained with Ethidium bromide, and visualized using UV trans illumination (Alpha Innotech, USA).
2.3. Preparation of cefazolin-containing niosomes
To prepare cefazolin-containing niosomes; span60 (sorbitan monostearate), cholesterol and polyethylene glycol 3000, and cefazolin with a molar ratio of 7:3:1:1 were mixed in a 2:1 of chloroform-methanol solution using thin-film hydration method [29]. The control sample was prepared with the same procedure without addition of antibiotic. The final mixture was stirred at 37 °C to obtain a homogenized suspension. The niosome suspension was poured into a round-bottom flask and gently rotated at 100 rpm on a rotary evaporator (WB Eco Laborota 4000 Model, Heidolph Instruments, GmbH) at 60 °C to remove the excess solvent until a thin lipid film was deposited on the wall of the flask. Then the final solid film was completely dried using nitrogen gas and suspended in 20 ml of 1 M phosphate buffer of pH 7.4 at 60 °C. All the prepared batches were visually observed for turbidity and flocculation in transparent containers while keeping at 4 °C.
2.4. Characterization of niosomes
2.4.1. Transmission electron microscopy (TEM)
TEM was conducted to evaluate the morphology, size, and uniformity of niosomes according to the 3001-1503-7 standards at the specialized laboratory of the Sharif University of Technology, Tehran, Iran. One drop of niosome suspension was placed on a carbon-coated grid for 2 min and the excess liquid was removed using filter paper. One drop of 2% uranyl acetate aqueous solution was added to niosomes for negative staining. Samples were examined after 3 min at room temperature using a digital camera at 80 kV accelerating voltage. The pictures taken during TEM were analyzed by ImageJ bundled with Java 1.8.0_172 software (National Institutes of Health, http://imagej.nih.gov/ij). The mean diameter of niosomes was determined using the Cilas laser diffraction particle size analyzer (Model 1064, Cilas, France) at RT. The size modification of cefazolin-loaded niosomes stored in the original solution was measured and monitored at 4 °C every 3 months.
2.4.2. Determination of particle size, size distribution and zeta potential of niosomes
Particle size, size distribution and zeta potential of niosomes were analyzed by Zeta-sizer instrument (Nano ZS3600, Malvern Instruments Ltd., Worcestershire, UK) equipped with a 633 nm He-Ne laser. The samples were analyzed at the same pH, concentration and temperature (pH7.4, 0.1 mg ml−1, 25 °C). The stability of niosomes was monitored during the storage condition (at 4 °C for 1 month) by measuring the particle size, polydispersity index (PDI), entrapment efficiency (EE %) and zeta potential.
2.4.3. Drug entrapment efficacy
To do this, 1 ml of 1 mg ml−1 of cefazolin-containing niosome suspension was centrifuged in an ultra Amicon tube with a 30 kDa cut-off and centrifuged at 7500 g for 25 min at RT. The optical density of unentrapped drug in supernatant was measured at 271 nm by spectrophotometer and its concentration was estimated using the standard curve. Finally, the EE % of drug into the niosomes was determined by the following equation:

2.4.4. Cell viability
Cell viability was measured with 3-(4,5-dimethylthiazol-2-yl)-2,5-diphenyl tetrazolium bromide (MTT) (Sigma, USA) using a colorimetric assay [30, 31]. Five thousand normal human fibroblasts were seeded in 100 μl of culture medium per well in 96-well plates and incubated for 24 h at 37 °C. Different concentrations of niosomes were added to the cells in triplicate and DMSO was used as the negative control. After 24 h incubation, the treated cells were washed by PBS (5 mgml−1). Two hundred microliters of MTT-contained culture medium with the final concentration of 500 μg ml−1 was added and incubated for 3 h at 37 °C. The culture medium was discarded and 100 μl of DMSO (Sigma, USA) was added. After 30 min incubation, the final absorbance was read at 570 nm with Epoch microplate spectrophotometer (USA). The cell viability percentage was calculated by the following formula (all experiments were performed in triplicate):

2.4.5. Confocal laser scanning microscopy (CLSM)
CLSM was carried out to investigate the effect of cefazolin-containing niosome against preformed biofilm of MRSA. Biofilm was grown on glass coverslips as previously described by Banas et al [31–33]. In brief, 6-well microtiter plates seeded with glass coverslips. Five milliliters of TSB with 2% glucose were added to each well. Three milliliters of mid-exponential grown bacterial culture in TSB were added aseptically to the wells following incubation at 37 °C for 24 h. Afterward, Cefazolin-loaded niosomes were added to the wells except for control wells, and the plate was incubated at 37 °C for 24 h. Then, the coverslips were removed and softly rinsed with sterile PBS and were stained with 15 μl propidium iodide (Sigma, USA) for 15 min at RT to discover dead bacterial cells. After being rinsed three times in PBS, 50 μl ml−1 of fluorescein isothiocyanate (FITC-Sigma, USA) was added to the wells for 15 min at RT to visualize the green glycocalyx matrix. The propidium iodide and FITC were excited at 540 nm and 630 nm, respectively. Their emission was separately observed at 490 nm and 535 nm, respectively. Untouched biofilms were analyzed using confocal electron microscopy (Leica TCs SP5 ll).
2.4.6. Minimal inhibitory and bactericidal concentrations (MIC and MBC)
The MIC and MBC of cefazolin and cefazolin-containing niosomes against all S. aureus and MRSA isolates were determined by the microtiter plate method as described by Wiegand [34].
2.4.7. Minimal biofilm eradication concentration (MBEC)
MBEC was carried out to evaluate the efficacy of cefazolin-containing niosome against MRSA biofilm. MRSA isolates were cultured on solid agar. Twenty microliters of serially diluted bacterial suspensions (108 CFU ml−1) was added to the wells of three sterile 96-well microtiter plates which were filled with 180 µl per well of TSB medium (Merck, USA) supplemented with 1% glucose in advance. The plates were incubated for 1 d, 3 d, and 3 d in separate groups at 37 °C. The wells were washed with 200 µl of sterile saline to remove the non-adherent cells. Hundred microliters of cation-adjusted nutrient broth was added to each well followed by 100 µl of cefazolin-containing niosome except for the control wells. The plates were incubated for 24 h at 37 °C and rinsed three times with sterile saline. The wells then were stained using a 2,3,5-triphenyl-tetrazolium chloride method [35]. The plates were read with an automated ELISA reader (Titertek, R Multiscan) at wavelength 470 nm.
2.4.8. Histopathology in vivo studies
Histopathology experiments were carried out to evaluate the effects of cefazolin and cefazolin-loaded niosome against MRSA biofilm‐mediated infections. A 5 mm full-thickness excision wound healing model [36] was created using a 5 mm biopsy punch in the dorsal skin of BALB/c mice. Polycaprolactone (PCL) scaffold provided by Fanavaran Nano-Meghyas Corporation (Fnm co. Ltd.) was punched with a 5 mm biopsy punch sterilized by UV radiation. The PCL pieces were put on the bottom of a sterilized petri dish and 20 ml of BHI broth inoculated with MRSA was poured on them and incubated for 24 h at 37. The mice were anesthetized with an appropriate amount of ketamine/xylazine based on their body mass following shaving their dorsal hair. A silicone ring (15 mm outer diameter and 6 mm inner diameter) covered around the wound by suturing to the dermis of the BALB/c mice. Then, biofilm-containing PCL pieces and wounds were placed in mice for 3 h except for the control group. Afterward, the nano-fibrous mats containing biofilms were removed and the wounds were treated by 3 ml of lyophilized cefazolin-containing niosomes, niosomes, and 3 M TegadermTM containing cefazolin except for the control group. Each group was kept in their post-operation cage on a 12 h light/dark cycle with access to food and tap water and libitum and received human care. On 21st day post-operation, the healed area on the dermis was removed and kept in a 10% formalin solution for further pathology investigations. Hematoxylin and eosin (H&E) staining were performed and the neutrophils, fibroblasts, epithelium layers, and vessels were counted to evaluate the healing progress. Ethical approval for this study was obtained from the Pasteur Institute of Iran (IR.PII.REC.1398.025).
2.4.9. Statistical analysis
Statistical analyses were performed using the one-way ANOVA test (IBM SPSS Statistics 26.0.0.1 FP001 IF007), with a statistically significant p-value < 0.05.
3. Results
3.1. S. aureus isolation and MRSA detection
Sixty of 80 clinical isolates were identified as S. aureus based on colony morphology, Gram's stain, and biochemical tests. Twenty-seven isolates were confirmed and identified as MRSA based on the mecA gene PCR amplification. The 310 bp-PCR product related to the mecA gene was detected in all 27 isolates after electrophoresis (figure 1).
Figure 1. PCR assay for detection of mecA gene, left to right: (M): marker (100 bp Ladder), (1): negative control, (2) positive Control: MRSA (ATCC6538); (3–12) samples.
Download figure:
Standard image High-resolution image3.2. Niosomes characterization
TEM micrographs showed that the niosomes were spherical in shape with approximately uniform size. The size of niosomes measured by TEM was obtained around 100 nm, while the particle diameter of niosomes measured by DLS was about 137 nm. Size distribution (PDI) of niosomes showed a proper uniformity and monodisperse quality for the particles (figures 2 and 3). The surface charge of the niosomes containing drug was obtained around −63 mV (figure 4). No significant difference in morphology, size, zeta potential and PDI were found between cefazolin-loaded niosomes and its control (drug free niosomes). The niosomal formulation was stable during the storage conditions (at 4 °C, for 1 month) and there was no significant change in particle size, PDI, zeta potential and EE %.
Figure 2. TEM micrographs of cefazolin-loaded niosomes (left) and its control (right). The particle diameter of the niosomes was calculated by Image J software.
Download figure:
Standard image High-resolution imageFigure 3. Size distribution curve of cefazolin-loaded niosomes (up) and its control (down) obtained by dynamic light scattering method.
Download figure:
Standard image High-resolution imageFigure 4. Zeta potential distribution curve of cefazolin-loaded niosomes (up) and its control (down). Zeta potential of cefazolin-loaded niosomes was calculated −63 mV with 0.272 ms cm−1 conductivity and 6.98 zeta deviation by zeta-sizer instrument.
Download figure:
Standard image High-resolution image3.3. Cefazolin EE %
Entrapment of antibiotics into the nanocarriers is known to improve their antimicrobial activities. Entrapment efficiency is a major factor that is considered in development of a drug delivery system. Achieving a high yield of EE % is directly correlated with therapeutic efficacy of the drug. In this study, the drug EE % was determined by the indirect method [37]. In this method, the unentrapped drug was estimated in the supernatant after centrifugation. Then the EE % was estimated as the difference between the total amount of drug and the unentrapped drug in the supernatant respect to the total amount of drug that initially incorporated into the nanocarrier formulation.
Here, high yield of EE % was obtained, so that the amount of drug encapsulated in the niosomal suspension was estimated around 95.71%.
3.4. Niosomes cytotoxicity
The results showed that cefazolin-loaded niosomes did not have cytotoxic effects on the host cells in 24 h, 48 h, and 72 h post-exposure. The mean value of viable cells in loaded and non-loaded niosomes was determined approximately 100% and equaled to the control group (figure 5).
Figure 5. Comparison of cell viability of cefazolin-loaded, non-loaded niosomes and control using MTT colorimetric assay. Viability percentage in both treated and control groups was determined approximately 100 (P-value < 0.0001).
Download figure:
Standard image High-resolution image3.5. Minimal inhibitory and bactericidal concentrations (MIC and MBC)
The MIC and MBC of cefazolin and cefazolin-containing niosomes against all 60 S. aureus including both methicillin-resistant and non-methicillin-resistant isolates were determined [38]. The MIC and MBC of cefazolin against MRSA were 256 µg ml−1 and 512 µg ml−1, respectively. The MIC and MBC of cefazolin against S. aureus were 128 µg ml−1 and 256 µg ml−1, respectively. The MIC and MBC of cefazolin-loaded niosomes against MRSA were 128 µg ml−1 and 256 µg ml−1, respectively. The MIC and MBC of cefazolin-loaded niosomes against S. aureus were 64 µg ml−1 and 128 µg ml−1, respectively (Table 1).
Table 1. MIC and MBC of cefazolin and cefazolin-loaded niosomes against MRSA and S. aureus.
| Organism | MICs (μg ml)−1 | MBCs (μg ml)−1 | ||
|---|---|---|---|---|
| Cefazolin (µg ml)−1 | Cefazolin-loaded niosomes (µg ml)−1 | Cefazolin (µg ml)−1 | Cefazolin-loaded niosomes (µg ml)−1 | |
| MRSA | 256 | 128 | 512 | 256 |
| S. aureus | 128 | 64 | 256 | 128 |
3.6. Minimal biofilm eradication concentration (MBEC)
The results of MBEC showed that cefazolin only inhibited S. aureus isolates in the 1 d old plate at the concentration of 256 µg ml−1 and had no inhibition effect on MRSA. Cefazolin-loaded niosome inhibited biofilm formation of both MRSA and S. aureus isolate at the concentration of 128 µg ml−1 and 64 µg ml−1, respectively (Table 2). In the 3 d old group, the MBEC of cefazolin-loaded niosome was 128 µg ml−1 for both MRSA and S. aureus. Cefazolin-loaded niosome inhibited biofilm formation of MRSA and S. aureus at the concentrations 256 µg ml−1 and 128 µg ml−1, respectively in a 5 d old plate. The elimination rate of cefazolin, cefazolin-loaded, and non-leaded niosomes on biofilm formation of MRSA and S. aureus isolates in 1 d, 3 d, and 5 d old plates are shown in figure 6.
Figure 6. Comparison of elimination rate of cefazolin, cefazolin-loaded and nonleaded niosomes against 1 d, 3 d and 5 d old biofilm of MRSA and S. aureus isolates. Cefazolin-loaded niosomes showed definitely higher biofilm elimination rate in all three plates. P-value < 0.0001.
Download figure:
Standard image High-resolution imageTable 2. MBEC values of cefazolin and cefazolin-loaded niosomes against 1 d, 3 d and 5 d old MRSA and S. aureus biofilms (ND: none determined).
| Organism | MBEC 1 d | MBEC 3 d | MBEC 5 d | |||
|---|---|---|---|---|---|---|
| Cefazolin (µg ml)−1 | Cefazolin-loaded niosomes (µg ml)−1 | Cefazolin (µg ml)−1 | Cefazolin-loaded niosomes (µg ml)−1 | Cefazolin (µg ml)−1 | Cefazolin-loaded niosomes (µg ml)−1 | |
| MRSA | ND | 128 | ND | 128 | ND | 256 |
| S. aureus | 256 | 64 | ND | 128 | ND | 128 |
3.7. CLSM analysis
The results of the biofilm assessment using CLSM images revealed that the mean value of the dead bacterial cells in cefazolin-loaded niosome was significantly higher compared to the control group. Viable bacterial cells were scarcely detectable in cefazolin-loaded niosome biofilms (figures 7(a) and (b)).
Figure 7. CLSM. MRSA 48 h old biofilms were established in cell imaging cover slips (Eppendorf) and treated with cefazolin-loaded niosomes (b). After 24 h incubation cells were stained with FITC and propidium iodide to evaluate the cell viability. (a) Un-treated biofilm.
Download figure:
Standard image High-resolution image3.8. Histopathology and in vivo results
Macroscopic monitoring of skins was conducted by the 21st day in all five groups (figure 8). The healing signs including wound closure and hair formation observed in wounds treated by niosomal cefazolin healed similar to non-bacterial contaminated wounds. Infected wounds treated by empty niosomes and non-treated bacterial contaminated wounds did not close properly and hair formation had not been observed.
Figure 8. Macroscopic examination of wound infection in mice 3rd, 10th and 21st day post-operation. A: Cefazolin-loaded niosomes, D: Cefazolin powder, E: non-loaded niosomes, B: bacterial contaminated control wound and C: non-bacterial contaminated control wound. The macroscopic investigation of the wound, showed that wounds treated by non-loaded niosomes did not healed as well as other treated or without treated groups.
Download figure:
Standard image High-resolution imageH & E staining was conducted on the 21st day-old model wounds (see figure 9). Histological experiments demonstrated high counts of neutrophils in niosome control and infected control groups. The fewest neutrophil count was observed in niosomal cefazolin treated group. The highest number of hair follicles (HF), fibroblasts, and vessels as well as the level of epithelialization was observed in wounds treated by niosomal cefazolin (figure 9).
Figure 9. Histopathology results of wound infection and H&E staining of wound tissues in Cefazolin-loaded niosomes, Cefazolin powder, non-loaded niosomes, and bacterial contaminated and non-bacterial contaminated control wounds. The wound treated with cefazolin-loaded niosomes had the lowest count of neutrophils and the highest number of HF, fibroblasts, levels of epithelialization and angiogenesis.
Download figure:
Standard image High-resolution image4. Discussion
Regarding physical features, our cefazolin-loaded niosomes had the criteria of an appropriate niosomal particle. They were morphologically spherical and well-organized with a mean particle size of 137 nm. It is indicated that the smaller size of niosomal particles leads to more effective antibacterial activity [39]. Additionally, the zeta potential of −63 mV implied high stability of our cefazolin-loaded niosomes because absolute zeta potential of 30 mV and higher showed more stability and appropriate dispersion due to electrostatic repulsion [40]. Despite the small size of our niosomes, the percentage of cefazolin entrapment in the primary cefazolin-loaded niosome batch was calculated at 95.71%. This high entrapment efficacy can result from its formulation containing span60 and cholesterol. It is proven that the entrapment efficacy is considerably affected by type and amount of surfactant as well as surfactant/cholesterol ratio [25, 41]. In 2014, Heba et al evaluated the anti-biofilm activity of vancomycin-loaded niosomes against S. aureus ATCC 6538p. In this study, the Span60/cholesterol molar ratio of 1:1 gave the efficacy of 49.8% [42]. In our study, the 7:3 molar ratio of Span60/cholesterol was used for noisome preparation which is proven by Manosroi, et al giving the highest entrapment efficacy [30]. The length of the alkyl chain of used surfactants is an important factor affecting the permeability of niosomes for drug entrapment and consequently on their antimicrobial effectiveness. In the study by Kashef et al [11], the MIC of the two different ciprofloxacin-loaded niosomal preparations (I and II) were compared to that of the free ciprofloxacin, against S. aureus ATCC 25923 and 24 clinical S. aureus isolates. The results showed that niosomal preparation I containing span40 reduced the MIC by two fold in only four clinical isolates, while preparation II containing span60 reduced the MIC of most clinical isolates by 8–32-fold, and three isolates lost their resistance phenotype.
The MIC and MBC of both cefazolin and niosomal cefazolin against MRSA were determined as twice as S. aureus which indicates higher potency of MRSA in antimicrobial resistance compared to non-methicillin-resistant strains of S. aureus. Cefazolin-loaded niosomes could decrease the MIC and MBC of both MRSA and S. aureus categories by two fold. It has been proven that the MIC is dependent on the size of niosomes, for instance, Akbari et.al produced ciprofloxacin nano-niosomes by sonication of primary niosomes [43]. The results of their study revealed lower MIC values for nano-niosomes compared to larger ones due to better interaction with bacterial membrane.
The results indicate the successful anti-biofilm capability of our cefazolin-load niosomes. The results of the MBEC assay showed no elimination effect against MRSA biofilms. However, cefazolin-loaded niosomes had a significantly higher biofilm elimination rate for both S. aureus and MRSA in all plates compared to other groups. The highest biofilm elimination rate of cefazolin-loaded niosomes was observed in 1 d old wells inoculated by both S. aureus and MRSA isolates. It is implied that niosomes containing antibiotics fused with the biofilm matrix and successfully transferred unchanged antibiotics to accumulated bacterial cells and improved drug penetration. The anti-biofilm effect of cefazolin-loaded niosomes was stably maintained in a 5 d old plate which suggests the appropriate efficacy of our niosomes in chronic exposure to the site of colonization which can lead to fewer drug usage and intake intervals. Also, the results of CLSM analysis showed a significant reduction of biofilm density and bacterial counts in niosomal cefazolin-treated coverslip.
Histopathological experiments were conducted to evaluate wound healing and tissue regeneration properties of cefazolin-leaded niosomes. In our study, nanofiber scaffolds were used as a surface-borne model biofilm. These nanofibers mimic the natural fibrous extracellular matrix of skin tissue, allow gas circulation, exudate absorption, and prevent microbial contamination [44]. Furthermore, they can be loaded with various biomolecules including antibacterial peptides, hormones, cytokines, etc. PCL fibers were used as our scaffold due to high permeability to a wide range of drugs and appropriate biocompatibility and considered a suitable candidate for controlled drug delivery [45, 46]. Macroscopic results of in vivo and in vitro examinations on our wound-model biofilm showed no bacterial contamination on the day 5th post wound infection. The results of H&E staining showed a significant increase in counts of healing factors including fibroblasts, neutrophils, and HF as well as the level of angiogenesis. The number of neutrophils as an inflammation index was approximately half to that of infected control. It seems that cefazolin-loaded niosomes successfully reduces inflammations in the site of infection and concurrently improved healing signs compared to free antibiotics and facilitated wound healing.
5. Conclusion
In conclusion, our cefazolin-loaded niosomes successfully reduce MIC and MBC of free cefazolin against staphylococcal isolates as well as MBEC. Intended nanoparticles with a proper zeta potential causing dispersion, suitable size, and high entrapment efficacy, can be effective for in vivo investigation. CLSM analysis also confirmed the biofilm eradication more specifically before using nanoparticles on defected mice skin. Moreover, cefazolin-loaded niosomes showed effective in vitro and in vivo anti-biofilm activity in wound models. Histopathology investigations showed a promising results which suggest the niosomes for further analysis before clinical trials. Our niosomal cefazolin can be applied variably for the treatment of nosocomial MRSA wound infection and make positive contributions in the healing processes of infected ulcers.
Conflict of interest
The authors declare that there is no conflict of interest.